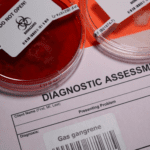

Category archive for ‘Health’ 
-

Difference Between Rumination and Regurgitation
-

Difference Between Suicide and Euthanasia
-

Difference Between Ophthalmology and Optometry
-

Difference Between PTSD and ASD
-

Difference Between Vector-Borne and Airborne Diseases
-

Difference Between Constipation and Bowel Obstruction
-

Difference Between Good Carbs and Bad Carbs
-

Difference Between Epidemic and Pandemic
-

Difference Between UTI and Yeast Infection
-

Difference Between Plant Protein and Animal Protein
-

Difference Between Schizophrenia and Psychosis
-

Difference Between Lymphoma and Leukemia
-

Difference Between Unsaturated and Saturated Fats
-

Difference Between Acetaminophen and Ibuprofen
-

Difference Between Doula and Midwife
-

Difference Between Dandruff and Dry Scalp
-

Difference Between AIDS and HIV
-

Difference Between Vaccination and Immunization
-

Difference Between Selective Mutism and Autism
-

Difference Between Stomach Flu and Food Poisoning
-

Difference Between Oxycontin and Oxycodone
-

Difference Between Dietitian and Nutritionist
-

Difference Between Cold and Sinus Infection
-

Difference Between Aerobic and Anaerobic Exercise
-

Difference Between Rheumatoid Arthritis and Osteoarthritis
-

Difference Between Oxycodone and Hydrocodone
-

Difference Between IVF and IUI
-

Difference Between Radiation and Chemo
-

Difference Between EMT and Paramedic
-

Difference Between Jogging and Running
-

Difference Between Crack and Cocaine
-

Difference Between Exocytosis and Endocytosis
-

Difference Between Hives and Rash
-

Difference Between Tumor and Cyst
-

Difference Between Depersonalization-Derealization and Dissociation
-

Difference Between Ganser Syndrome and Munchausen
-

Difference Between Good and Bad Cholesterol
-

Difference Between Caesarian Section and Normal Birth
-

Difference Between Somatic and Psychosomatic
-

Difference Between Sore Throat and Strep Throat
-

Difference Between a Psychologist and a Psychiatrist
-

Difference Between Sacroiliitis and Sciatica
-

Difference Between Hordeolum and Chalazion and Blepharitis
-

Difference Between Somatic Hypermutation and Class Switching
-

Difference Between Zollinger-Ellison Syndrome and Gastrinoma
-

Difference Between Somatic Hypermutation and Affinity Maturation
-

Difference Between Social Anxiety Disorder and Depression
-

Difference Between Dissociative Identity Disorder and Borderline Personality Disorder
-

Difference Between Depersonalization-Derealization and Dissociation
-

Difference Between Yoga and Pilates
-

Difference Between Birth Control and Morning After Pill
-

Difference Between Hordeolum and Chalazion
-

Difference Between Somatic and Cognitive Anxiety
-

Difference Between Sciatica and Bursitis
-

Difference Between Trismus and Lockjaw
-

Difference Between Pericoronitis and Periodontitis
-

Difference Between Panhypopituitarism and Hypopituitarism
-

Difference Between Niemann Pick Disease and Tay Sachs
-

Difference Between Hyposmia and Anosmia
-

Difference Between Hypopituitarism and Hyperpituitarism
-

Difference Between Gonorrhea and Trichomoniasis
-

Difference Between Vesicles and Papules
-

Difference Between Cubital Tunnel Syndrome and Carpal Tunnel Syndrome
-

Difference Between DHEA and Testosterone
-

Difference Between Vascular Cambium and Cork Cambium
-

Difference Between Bullous Impetigo and Bullous Pemphigoid
-

Difference Between Immediate and Delayed Hypersensitivity
-

Difference Between Blepharitis and Preseptal Cellulitis
-

Difference Between Vesicular and Pustular
-

Difference Between Acute and Chronic Insomnia
-

Difference Between Vesicular and Bronchial Breath Sounds
-

Difference Between Bell’s Palsy and Trigeminal Neuralgia
-

Difference Between Ramsay Hunt Syndrome and Shingles
-

Difference Between Vascular Cambium and Cork Cambium
-

Difference Between Pustules and Whiteheads
-

Difference Between Pustules and Papules
-

Difference Between Goiter and Hyperthyroidism
-

Difference Between Canonical and Noncanonical
-

Difference Between Anavar and Deca
-

Difference Between Diuretics and Laxatives
-

Difference Between Somatic Delusions and Hypochondriasis
-

Difference Between Nosophobia and Hypochondriasis
-

Difference Between Dwarfism and Cretinism
-

Difference Between Mucous Membrane Pemphigoid and Pemphigus Vulgaris
-

Difference Between Arachnoiditis and Sciatica
-

Difference Between Hypochondria and Munchausen
-

Difference Between Hypo Goiter and Hyper Goiter
-

Difference Between Werner Syndrome and Progeria
-

Difference Between Pustules and Cysts
-

Difference Between Liver Fibrosis and Cirrhosis
-

Difference Between Liver and Kidney Function
-

Difference Between Raynaud’s Syndrome and Disease
-

Difference Between Parasomnia and Dyssomnia
-

Difference Between Central and Peripheral Facial Nerve Palsy
-

Difference Between Pemphigus Foliaceus and Vulgaris
-

Difference Between Paroxysmal Hemicrania and Cluster Headache
-

Difference Between Somatic Cells and Gamete
-

Difference Between Goiter and Fat Neck
-

Difference Between Couperose and Rosacea
-

Difference Between Conversion Disorder and Somatization
-

Difference Between Bell’s Palsy and Lyme Disease
-

Difference Between Palpitations and Arrhythmia
-

Difference Between Somatization and Hypochondriasis
-

Difference Between Rectocele and Rectal Prolapse
-

Difference Between Cystocele and Rectocele
-

Difference Between Rosacea and Malar Rash
-

Difference Between DHEA and DHA
-

Difference Between Femoral Nerve Pain and Sciatica
-

Difference Between Toxic and Nontoxic Goiter
-

Difference Between Somatic and Visceral Pain
-

Difference Between Somatic and Germline Mutations
-

Difference Between Sciatica and Radiculopathy
-

Difference Between Piriformis Syndrome and Sciatica
-

Difference Between Normal Neck and Goiter
-

Difference Between Loop Diuretics and Thiazide Diuretics
-

Difference Between Enterocele and Rectocele
-

Difference Between Rosacea and Butterfly Rash
-

Difference Between Somatic and Visceral
-

Difference Between Dizziness and Tinnitus
-

Difference Between Ramsay Hunt Syndrome and Bell’s Palsy
-

Difference Between Diuretics and Antidiuretics
-

Difference Between DHEA and Pregnenolone
-

Difference Between Carpal Tunnel Syndrome and RSI
-

Difference Between Blepharitis and Hordeolum
-

Difference Between Blepharitis and Chalazion
-

Difference Between Anterolisthesis and Spondylolisthesis
-

Difference Between Anterolisthesis and Retrolisthesis
-

Difference Between Celiac Disease and Gluten Sensitivity
-

Difference Between Sciatica and Lower Back Pain
-

Difference Between Sciatica and Herniated Disc
-

Difference Between Pemphigoid Gestationis and Puppp
-

Difference Between Palpitations and Tachycardia
-

Difference Between Hip Pain and Sciatica
-

Difference Between DHEA and DHEAS
-

Difference Between Bullous Pemphigoid and Pemphigus Vulgaris
-

Difference Between Blepharitis Anterior and Blepharitis Posterior
-

Difference Between a Lupus Rash and Rosacea
-

Difference Between Bell’s Palsy and Stroke
-

Difference Between Blepharitis and Conjunctivitis
-

Difference Between Acne Rosacea and Acne Vulgaris
-

Difference Between Polymyalgia Rheumatica and Giant Cell Arteritis
-

Difference Between Cancerous Tumors and Noncancerous Tumors
-

Difference Between Streptococcus Pneumoniae and Mycoplasma Pneumoniae
-

Difference Between Paget’s Disease and Osteosarcoma
-

Difference Between Pulmonary Embolism and Deep Vein Thrombosis
-

Difference Between Chronic Lymphocytic Leukemia and Acute Lymphoblastic Leukemia
-

Difference Between Gastroesophageal Reflux Disease (GERD) and Peptic Ulcer Disease
-

Difference Between Mesothelioma and Lung Cancer
-

Difference Between Barrett’s Esophagus and GERD
-

Difference Between Type 1 Hypersensitivity and Type 4 Hypersensitivity
-

Difference Between Psoriatic Arthritis and Rheumatoid Arthritis
-

Difference Between Polycystic Ovary Syndrome PCOS and Endometrial Cancer
-

Difference Between Mental Health Disorders and Neurodevelopmental Disorders
-

Difference Between Pancreatitis and Pancreatic Cancer
-

Difference Between Hemorrhoids and Anal Fissures
-

Difference Between Hemophilia A and Hemophilia B
-

Difference Between Endometriosis and Uterine Fibroids
-

Difference Between Depression and Grief
-

Difference Between Chronic Fatigue Syndrome and Fibromyalgia
-

Difference Between Cholecystitis and Cholangitis
-

Difference Between Bursitis and Tendinitis
-

Difference Between Osteoporosis and Osteopenia
-

Difference Between Burp and Hiccup
-

Difference Between Coronary Artery Disease and Congestive Heart Failure
-

Difference Between Meningitis and Encephalitis
-

Difference Between Hirschsprung’s Disease and Inflammatory Bowel Disease
-
Difference Between Cushing’s Syndrome vs. Addison’s Disease
-
Difference Between Typhoid and Yellow Fever
-

Difference Between TB Ulcer and Typhoid Ulcer
-

Difference Between Paresthesia and Neuropathy
-

Difference Between Paresthesia and Paralysis
-

Difference Between Pertussis and Tuberculosis
-

Difference Between Interstitial Cystitis and Overactive Bladder
-

Difference Between Hypertrichosis and Hirsutism
-

Difference Between Anomaly and Abnormality
-

Difference Between Chronic Glomerulonephritis and Chronic Interstitial Nephritis
-

Difference Between Undescended Testis and Ectopic Testis
-
Difference Between Tingling and Twitching
-

Difference Between Erectile Dysfunction and Premature Ejaculation
-

Difference Between Esophageal Cancer and Stomach Cancer
-

Difference Between Raynaud’s Disease and Frostbite
-

Difference Between Mitral Valve Prolapse and Aortic Valve Stenosis
-

Difference Between Hematoma and Blood Blister
-

Difference Between Gastritis Endoscopy and Normal
-

Difference Between Bordetella Pertussis and Parapertussis
-

Difference Between AA and Al-Anon
-

Difference Between Osteoporosis and Osteomyelitis
-

Difference Between Trypanosoma Gambiense and Rhodesiense
-

Difference Between Normal Stomach and Gastritis
-

Difference Between Necrotizing Fasciitis and Cellulitis
-

Difference Between Gastritis and Ulcer
-
Difference Between Gas Gangrene and Necrotizing Fasciitis
-

Difference Between Fournier’s Gangrene and Necrotizing Fasciitis
-

Difference Between Type I and Type II Necrotizing Fasciitis
-

Difference Between Cholera and Typhoid
-

Difference Between Granulomatous and Non-Granulomatous
-

Difference Between Typhoid Vaccine Oral and Injection
-

Difference Between Gastritis and Acid Reflux
-

Difference Between Gastritis and Esophagitis
-

The Difference Between Gastritis and Pancreatitis
-

Difference Between Acute Gastritis and Chronic Gastritis
-

Difference Between Viral and Bacterial Gastroenteritis
-

Difference Between Gastritis and GERD
-

Difference Between Gastritis and Gastroenteritis
-

Difference Between Gastritis and Diarrhea
-

Difference Between Paresthesia and Dysesthesia
-

Difference Between Septal Hematoma and Polyp
-

Difference Between Extradural Hematoma and Subdural Hematoma
-

Difference Between Typhoid and Paratyphoid
-

Difference Between Acute and Chronic Osteomyelitis
-

Difference Between Plasmodium Falciparum and Vivax
-

Difference Between Parainfluenza in Dogs and Bordetella
-

Difference Between Malaria and Sickle Cell Anemia
-

Difference Between Hematoma and Abscess
-

Difference Between Hematoma and Hemorrhage
-

Difference Between Fetal Alcohol Syndrome and Down Syndrome
-

Difference Between Aneurysm and False Aneurysm
-

Difference Between the Morel-Lavallee Lesion and Hematoma
-

Difference Between Bruise and Abrasion
-

Difference Between Bradykinesia and Dyskinesia
-

Difference Between Healing and Infected Belly Button Piercing
-

Difference Between Salmonellosis and Typhoid Fever
-

Difference Between Fasciculations and Myokymia
-

Differences Between Osteomyelitis and Septic Arthritis
-

Difference Between Periapical Granuloma and Cyst
-

Difference Between Hematoma and Melanoma
-

Difference Between Bruising and Necrosis
-

Difference Between Brain Hematoma and Brain Hemorrhage
-

Difference Between Bordetella and Kennel Cough
-

Difference Between Subdural Hematoma and Stroke
-

Difference Between Intramural Hematoma and Dissection
-

Difference Between Typhoid and Dengue
-

Difference Between Retractile Testis and Undescended Testis
-

Difference Between Hematoma and Hemangioma
-

Difference Between Bruise and Purpura
-

Difference Between Granuloma Annulare and Tinea Corporis
-

Difference Between Hemorrhage and Infarct
-

Difference Between Hematoma and Pseudoaneurysm
-

Difference Between Ulcerative Colitis and Diverticulitis
-

Difference Between Hemorrhage and Aneurysm
-

Difference Between Granuloma and Keloid
-

Difference Between Acute Subdural Hematoma and Chronic
-

Difference Between Subungual Hematoma and Melanoma
-

Difference Between Typhoid and Typhus
-

Difference Between Perianal Hematoma and Hemorrhoids
-

Difference Between Hematoma and Blood Clot
-

Difference Between Umbilical Granuloma and Polyp
-

Difference Between Cytokinesis and Karyokinesis
-

Difference Between Hematoma and Seroma
-

Difference Between Toenail Hematoma and Melanoma
-

Difference Between Thyrotoxicosis and Thyroid Storm
-

Difference Between Malaria and Typhoid Symptoms
-

Difference Between Giardiasis and Amebiasis
-

Difference Between Diphtheria and Tonsillitis
-

Difference Between Diphtheria and Strep Throat
-

Difference Between a Cochlear Implant and Normal Hearing
-

Difference Between Inflammation and Allergy
-

Difference Between Actinic Keratosis and Solar Keratosis
-

Difference Between Akinesia and Apraxia
-

Difference Between Hamartoma and Hemangioma
-

Difference Between Obstructive and Restrictive Spirometry
-

Difference between Type 1 and Type 2 Diabetes
-

Difference Between Ecchymosis and Petechiae
-

Difference Between Thrombolytic and Antiplatelet
-

Difference Between Anticoagulants and Fibrinolytics
-

Difference Between Ecchymosis and Erythema
-

Difference Between Bruising and Internal Bleeding
-

Difference Between Aortic Ectasia and Aneurysm
-

Difference Between Narcolepsy Brain and Normal Brain
-

Difference Between Auditory Brainstem Implant and Cochlear Implant
-

Difference Between Hamartoma and Teratoma
-

Difference Between Ecchymosis and Contusion
-

Difference Between Bruising and Hematoma
-

Difference Between Hamartoma and Choristoma
-

Difference Between Cataplexy and Catalepsy
-

Difference Between Bruxism and Sleep Apnea
-

Difference Between Ecchymosis and Hematoma
-

Difference Between Spirometry and Pulmonary Function Test
-

Difference Between Cochlear Implant and Hearing Aid
-

Difference Between Achalasia and GERD
-

Difference Between Guided and Unguided Meditation
-

Difference Between Spirometry for Asthma and Spirometry COPD
-

Difference Between Agglutination and Coagulation
-

Difference Between Neuromodulation and Neurostimulation
-

Difference Between Spirometry and Peak Flow Meter
-

Difference Between Neuromodulator Injections and Botox
-

Difference Between Adenosis and Adenoma
-

Difference Between Gallstones and Polyps
-

Difference Between Lecithin and Lectin
-

Difference Between Achalasia and Pseudoachalasia
-

Difference Between Convalescent Plasma and IVIG
-

Difference Between Achalasia and Gastroparesis
-

Difference Between Blood Clot and Muscle Pain
-

Difference Between Extrinsic and Intrinsic Blood Clotting Pathways
-

Difference Between Procoagulant and Anticoagulant
-

Difference Between Peritoneum and Retroperitoneum
-

Difference Between Celiac Disease and Ulcerative Colitis
-

Difference Between Amyloid and Tau
-

Difference Between Turner Syndrome and Klinefelter Syndrome
-

Difference Between Lecithin and Choline
